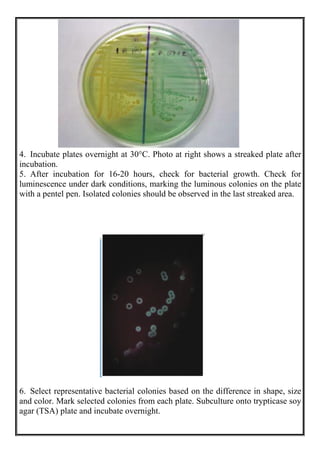
4. Incubate plates overnight at 30°C. Photo at right shows a streaked plate after
incubation.
5. After incubation for 16-20 hours, check for bacterial growth. Check for
luminescence under dark conditions, marking the luminous colonies on the plate
with a pentel pen. Isolated colonies should be observed in the last streaked area.
6. Select representative bacterial colonies based on the difference in shape, size
and color. Mark selected colonies from each plate. Subculture onto trypticase soy
agar (TSA) plate and incubate overnight.

This document discusses methods for isolating bacteria from mixed cultures in order to obtain a pure culture of a single bacterial species. It describes several techniques used for isolation including streaking, plating, dilution, enrichment procedures, and single cell techniques. Streaking is the most widely used method and involves streaking bacteria across an agar plate with a sterile loop or needle to separate individual colonies. Other methods like plating, dilution, and enrichment procedures help isolate bacteria by taking advantage of differences in growth rates or nutritional requirements. Obtaining a pure culture of a single bacterial species is the first step in identifying bacteria that may cause disease.